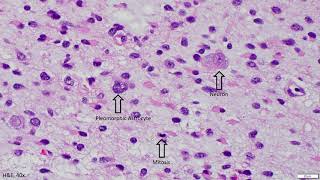

Diffuse Astrocytoma IDH mutant Adventures in Neuropathology video
Online izle ve mp4 mp3 formatlarinda yukle

Videonun muddeti: 7:09
Diffuse Astrocytoma IDH mutant Adventures in Neuropathology videosu mp4 ve mp3 yuklemek ucun hazirdir
Diqqet! Siz Mp4 yukle ve ya Mp3 yukle duymesine basdiqdan sonra eger sistem sizi reklam sehifesine atarsa o zaman derhal geri qayidib emeliyyati tekrar edin ve faylin yuklemek ucun hazir olmasini gozleyin
Videodan Mp4 Yukle
Videodan Mp3 Yukle-1
Videodan Mp3 Yukle-2
Oxshar Axtarishlar
 Diffuse Astrocytoma IDH mutant - Adventures in Neuropathology
Diffuse Astrocytoma IDH mutant - Adventures in Neuropathology IDH - Mutant Astrocytoma: Update from the 5th Edition WHO Classification of CNS Tumors
IDH - Mutant Astrocytoma: Update from the 5th Edition WHO Classification of CNS Tumors IDH - Wildtype Astrocytoma: Update from the 5th Edition WHO Classification of CNS Tumors
IDH - Wildtype Astrocytoma: Update from the 5th Edition WHO Classification of CNS Tumors Glioblastoma histopathologic diagnosis - Adventures in Neuropathology
Glioblastoma histopathologic diagnosis - Adventures in Neuropathology Pathology Grand Rounds | Dr. PJ Cimino
Pathology Grand Rounds | Dr. PJ Cimino Ependymoma explained. - Adventures in Neuropathology
Ependymoma explained. - Adventures in Neuropathology Vorasidenib in IDH-Mutant Glioma | NEJM
Vorasidenib in IDH-Mutant Glioma | NEJM Diffuse Astrocytoma, IDH-Mutant, WHO Grade II
Diffuse Astrocytoma, IDH-Mutant, WHO Grade II Advances in Therapy for Gliomas
Advances in Therapy for Gliomas
Video Mp4 Mp3Azwap.Biz
Azwap.Biz 2021-2023

Diffuse Astrocytoma IDH mutant - Adventures in Neuropathology
Diffuse Astrocytoma IDH mutant - Adventures in Neuropathology IDH - Mutant Astrocytoma: Update from the 5th Edition WHO Classification of CNS Tumors
IDH - Mutant Astrocytoma: Update from the 5th Edition WHO Classification of CNS Tumors IDH - Wildtype Astrocytoma: Update from the 5th Edition WHO Classification of CNS Tumors
IDH - Wildtype Astrocytoma: Update from the 5th Edition WHO Classification of CNS Tumors Glioblastoma histopathologic diagnosis - Adventures in Neuropathology
Glioblastoma histopathologic diagnosis - Adventures in Neuropathology Pathology Grand Rounds | Dr. PJ Cimino
Pathology Grand Rounds | Dr. PJ Cimino Ependymoma explained. - Adventures in Neuropathology
Ependymoma explained. - Adventures in Neuropathology Vorasidenib in IDH-Mutant Glioma | NEJM
Vorasidenib in IDH-Mutant Glioma | NEJM Diffuse Astrocytoma, IDH-Mutant, WHO Grade II
Diffuse Astrocytoma, IDH-Mutant, WHO Grade II Advances in Therapy for Gliomas
Advances in Therapy for Gliomas